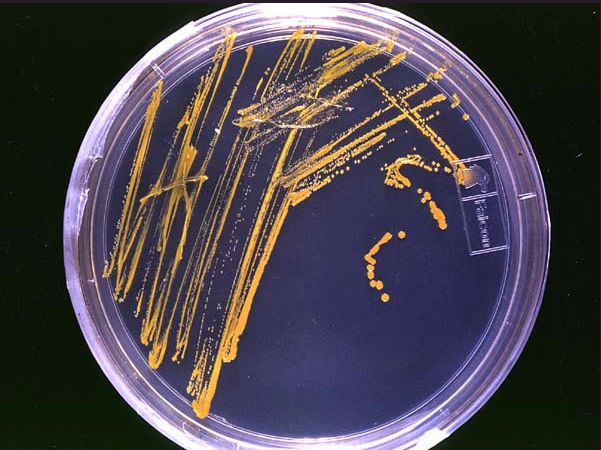

Driving innovation excellence in Latvia with Natalion, a natural products research project
Long before the advent of modern molecular medicine, natural products were the cornerstone of treating diseases and alleviating symptoms. Today, natural products remain a key source for drug development, with over 30% of currently used pharmaceuticals being derived from natural sources or their analogues. Iconic examples are: penicillins, for treating bacterial infections; statins, for lowering cholesterol levels; artemisinins, for treating malaria; paclitaxel, for treating cancer; and galantamine, to combat memory loss. Other natural products are used in agriculture as herbicides, fungicides, and insecticides, and in veterinary medicine. Compared with synthetic compounds, natural products offer unique chemical features that contribute to their biological activity, selectivity, and bioavailability.
Interest in natural product research declined in the 1990s, largely because of the complicated discovery process involving identifying active compounds, dereplication, and isolating and characterizing them, along with the belief that high throughput screening of large chemical libraries was sufficient to provide a sufficient number of lead molecules for further development. However, we are now aware that we cannot afford to neglect natural products as a source of drug leads. Modern advances in analytical tools, biotechnology, genomics, and genetic engineering have reignited this field, opening new avenues for solutions to pressing global health challenges such as antimicrobial resistance and targeted therapies for cancer.
ERA Chair project NATALION
Recognizing the renewed potential of natural products in chemical biology, the Latvian Institute of Organic Synthesis (LIOS) has embraced this trend to strengthen its drug discovery capabilities. To advance this ambition, LIOS applied for and was awarded the Horizon Europe ERA Chair project NATALION (Natural Products Research at LIOS as a Driver for Excellence in Innovation).

I (Stefano Donadio, editor’s note) serve as ERA Chair of the NATALION project, providing its strategic guidance. I am co-founder and director of the Italian company NAICONS and bring over 40 years of experience in natural product research and industrial drug discovery, including contributions to the development of the antibiotics dalbavancin and ramoplanin. NAICONS is also a partner in the NATALION project.
The NPR group at the forefront of natural products research

As part of NATALION, LIOS has established a dedicated Natural Products Research (NPR) group. Headed by Dr. Chin-Soon Phan, the group is a dynamic team cultivating a vibrant ecosystem capable of producing both high-impact discoveries and practical solutions for industry. «My lab aims to better understand and harness nature’s evolved chemistry across all forms of life», says Dr. Chin-Soon Phan.
The group’s scientific focus spans several interconnected areas. They identify and isolate biologically active natural products from microorganisms, including species characteristic of the Baltic region, using advanced mass spectrometry, chromatography, and NMR spectroscopy. To understand how nature produces these compounds, the team employs heterologous gene expression in Escherichia coli, elucidating the biosynthetic pathways behind complex natural molecules. Evolution-inspired genome analysis and bioinformatics are also central to the approach, enabling visualization and functional analysis of proteins involved in natural product biosynthesis. Complementing these studies, the team investigates enzymatic mechanisms using structural predictions, mutagenesis, and in vitro characterization to uncover the chemistry driving natural product formation.
Building on these broad capabilities in natural product discovery and biosynthesis, the group is increasingly turning its attention to peptide-based molecules – particularly cyclic peptides. Peptide cyclization is an important chemical feature that improves proteolytic stability, cell permeability, and binding affinity. Cyclic peptides have become increasingly successful in therapeutics, with approximately one new cyclic peptide drug approved each year. In Dr. Phan’s opinion, peptide macrocyclase and cross-linking enzymes will be the key strategies for generating diverse cyclic peptides for drug discovery. One of the most important discoveries from the NPR group is the His-C2–Tyr-O4 and Trp-C5–Arg-Cγ cross-links catalyzed by enzymes ShyB and WprB, respectively.
Translating research into industrial partnerships
In addition to its scientific discoveries, the NPR group has developed a portfolio of services aimed at supporting industrial partnerships. These offerings include the provision of crude extracts from Baltic-area microorganisms for biological screening and research, fractionation of complex mixtures to isolate specific bioactive components, and purification of natural compounds from crude or fractionated extracts for further study or potential commercial application. The group also performs chemical profiling and identification, characterizing the constituents of microbial extracts or purified substances. These services are designed to facilitate the development of new compounds, early-stage drug discovery, and industrial R&D, positioning NATALION as a bridge between fundamental science and innovation-driven applications.
Accelerating innovation across LIOS
To further bridge research and application, NATALION has launched the LIOS Innovation Hub as a new institutional unit. LIOS Innovation Hub is designed as a platform not only to accelerate the translation of discoveries in natural products into commercialisable innovations but also to foster innovation across LIOS as a whole. By providing the expertise and support for interdisciplinary projects, the Hub strengthens the institute’s capacity to turn scientific insights into tangible solutions, positioning LIOS as a regional center of excellence for innovation-driven research and technology development.
Over the course of my career, I have witnessed several cycles of rising and declining interest in natural products. It is particularly exciting to be working during a renewed phase of strong momentum in this field. Thanks to today’s analytical, biological, and computational tools, natural products can once again make major contributions to addressing the societal challenges we currently face.
| LIOS is the leading centre in medicinal chemistry and preclinical pharmaceutical development in the Baltic states, excelling in drug discovery and development for treating cancer, cardiovascular, infectious, and central nervous system diseases. Its track record includes 18 original and ~100 generic medicines on the market, with 3 more currently under clinical trials by LIOS partners. NAICONS, established in 2013 and based in Milan, Italy, is a biotechnology company providing R&D services in the field of microbial products to partners in industry and academia. Its main asset is the micro4all Platform, which includes a collection of 45,000 actinomycete strains, a library of over 77,000 microbial fermentation extracts, and a database of over 150,000 molecules produced by a portion of its proprietary strains. |
This article was prepared with the support of the EU project No. 101087181 “Natural Products Research at Latvian Institute of Organic Synthesis as a Driver for Excellence in Innovation”.
References:
- Haedar, J. R., Kumari, G. S., Kiselov, V., Romanuks, V., Smits, G., Donadio, S., & Phan, C.-S. (2026). P450 cyptide synthase KwwB catalyzes Trp-C5–Trp-N1 cross-linking and accepts diverse precursor peptides. Organic Letters.
- Khan, A. H., Haedar, J. R., Kiselov, V., Romanuks, V., Smits, G., Donadio, S., & Phan, C.-S. (2025). P450 cyptide synthase MpoB catalyzes the cross-linking of the YPW motif on the precursor peptide. RSC Chemical Biology.
- Khan, A. H., Haedar, J. R., Kiselov, V., Romanuks, V., Smits, G., Donadio, S., & Phan, C.-S. (2025). P450 biarylitide synthase ShyB catalyzes cross-link between His-C2 and Tyr-O4 on the precursor peptide. Organic Letters.
- Khan, A. H., Haedar, J. R., Kiselov, V., Romanuks, V., Smits, G., Donadio, S., & Phan, C.-S. (2025). Radical SAM enzyme WprB catalyzes uniform cross-link topology between Trp-C5 and Arg-Cγ on the precursor peptide. ACS Chemical Biology.




